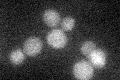
YOL002C
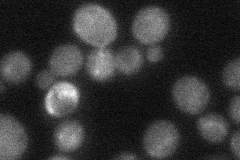
YOL002C
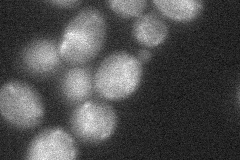
YOL002C
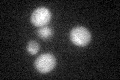
YOL002C

View description
Plasma membrane protein involved in zinc homeostasis and osmotin-induced apoptosis; transcription regulated by Zap1p, zinc and fatty acid levels; similar to mammalian adiponectins; deletion increases sensitivity to elevated zinc
Localization:
Intensity:
Fold change:
Significance:
-
C’ GFP library in SD
below threshold14.13 -
N' NOP1pr-GFP in SD

ER,punctate69.3179 -
N' TEF2pr-mCherry in SD

cell periphery,vacuole77.4743 -
N' NATIVEpr-GFP in SD
below threshold30.0669 -
N' TEF2pr-VC and Cyto-VN in SD
cytosol30.0147 -
C’ GFP library in SD+DTT
cytosol14.030.99No -
C’ GFP library in SD+H2O2

cytosol15.241.07No -
C’ GFP library in Starvation Media

cytosol14.581.03No -
C’ GFP library on the background of Pup2-DaMP

below threshold -
C’ GFP library on the background of CCT mutant

below threshold15.08661.06717No
